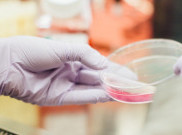

Lifestyle
Pertunjukan Musikal Keluarga Cemara 2025: Perpaduan Cerita Klasik dan Teater Megah
Musikal ini mengajak penonton untuk kembali merenungi nilai-nilai penting dalam keluarga.
Febrian Adi - Jumat, 20 Juni 2025

Lifestyle
Nadhif Kembangkan Debut Albumnya Lewat ‘Nadhif (laman berikutnya)’ yang Lebih Personal
Dalam versi deluxe ini, Nadhif Basalamah memperluas cakupan cerita dan ekspresi musikalnya dengan total 16 lagu.
Febrian Adi - Jumat, 20 Juni 2025

Indonesia
YouTube Music Bikin Kamu Bisa Pamer Lirik Lagu di Instagram Stories, Begini Caranya!
Fitur ini tersedia untuk semua pengguna, baik gratis maupun premium, di perangkat Android dan iOS
Febrian Adi - Jumat, 20 Juni 2025

Lifestyle
Album Origin, Karya Terakhir Donny Suhendra yang Dirampungkan Para Sahabat 3 Tahun Setelah Kepergiannya
Album berjudul Origin menjadi persembahan pamungkas Donny, sebuah karya yang belum sempat rampung saat ia masih hidup
Febrian Adi - Jumat, 20 Juni 2025

ShowBiz
Ammir Gita, Sujiwo Tejo, hingga Sita Nursanti Kolaborasi dalam SEMAR, Proyek Musik Penuh Jiwa
Komposer Ammir Gita bersama Suku Cahaya Ensemble menghadirkan karya bertajuk SEMAR.
Febrian Adi - Jumat, 20 Juni 2025

ShowBiz
Deretan Musisi Top Indonesia yang Masuk Grup WhatsApp 'Gemini Gemini' Milik Ahmad Dhani
Ahmad Dhani percaya zodiak Gemini memiliki pengaruh besar di dunia.
Febrian Adi - Jumat, 20 Juni 2025

ShowBiz
'A Tribute to Freddie King & Eric Clapton': Persembahan Arya Novanda yang Intim dan Jujur
Arya Novanda menghidupkan kembali semangat mentah dan soulful dari Freddie King dan Eric Clapton
Febrian Adi - Jumat, 20 Juni 2025

ShowBiz
Perunggu Rilis Single 'Pikiran Yang Matang' Buah dari Refleksi Mendalam, Simak Lirik Lengkapnya
Ide lagu Pikiran Yang Matang Perunggu lahir dari puasa media sosial.
Febrian Adi - Jumat, 20 Juni 2025

ShowBiz
Lagu Killin' It Girl dari J-Hope Tembus Trending YouTube, Simak Lirik Lengkapnya
Single Killin' It Girl merupakan rilisan terbaru dari J-Hope BTS.
Febrian Adi - Jumat, 20 Juni 2025

ShowBiz
Lagu 'Kawin Kontrak' dari Kades Hoho Alkaf dan Lala Widy Trending di YouTube, Berikut Lirik Lengkapnya
Lagu Kawin Kontrak mengisahkan tentang seorang pria yang mulai menumbuhkan rasa cinta terhadap pasangan dalam pernikahan kontraknya.
Febrian Adi - Jumat, 20 Juni 2025

ShowBiz
Lirik Lengkap 'STYLE' Tentang Romansa Remaja dari Hearts2Hearts
Menghadirkan tema cinta remaja yang manis dan relatable, menggambarkan perasaan berbunga-bunga khas masa muda.
Febrian Adi - Jumat, 20 Juni 2025

Lifestyle
Lirik Lagu 'Million Places' Menyampaikan Makna Mendalam Tentang Waktu dari XG
Lagu 'Million Places' punya pesan yang disampaikan penuh emosi melalui lirik dan aransemen yang menyentuh
Febrian Adi - Jumat, 20 Juni 2025

Lifestyle
Caffeine Mengeksplorasi Gaya Musikal Lebih Minimalis lewat Lagu 'Setangkai Bunga', Berikut Liriknya
Caffeine sekaligus memperkenalkan warna vokal baru dari Chikin yang terdengar lebih kalem dan matang.
Febrian Adi - Jumat, 20 Juni 2025

Lifestyle
‘Intro’ Iringi Tren ‘Ariana Grande Duduk' yang Viral di TikTok, Berikut Lirik Lengkapnya
Salah satu lagu lama milik Ariana Grande yang berjudul "Intro" belakangan ini kembali mencuri perhatian publik setelah viral di platform TikTok.
Febrian Adi - Kamis, 19 Juni 2025

ShowBiz
Lirik Lagu 'Dada' Aftershine, Single Patah Hati yang Populer di YouTube
Lagu Dada menggambarkan proses melepaskan dengan lapang dada, meskipun masih ada rasa sayang yang tertinggal.
Febrian Adi - Kamis, 19 Juni 2025

Fun
Varian Baru Rasa 'Anggur Merah' dari Brand Ternama Lokal
BINTANG keluarkan varian rasa 'Anggur Merah'
Febrian Adi - Rabu, 07 Juni 2023

ShowBiz
MyFest.ID Siap Menghentak Bandung pada 1 Juli 2023
MyFest.ID akan digelar pada Juni 2023.
Febrian Adi - Rabu, 07 Juni 2023

Lifestyle
Koleksi Spesial MONDIAL Tampil di Enchated Moment Wedding Fair 2023
Koleksi perhiasan terkini dari Mondial hadir dalam pameran EMWF.
Febrian Adi - Selasa, 06 Juni 2023

ShowBiz
Mezzaluna Jelajahi Isi Kota di Malam Hari lewat 'Setting Up the Phone Cell'
Mezzaluna lepas lagu keempat.
Febrian Adi - Selasa, 06 Juni 2023

ShowBiz
Man With A Mission Ungkap Tren Musik Jepang Jangkau Pendengar lewat Anime
Bisa dibilang, cara termudah bagi orang untuk mendengarkan musik keren Jepang ialah melalui anime.
Febrian Adi - Selasa, 06 Juni 2023

ShowBiz
Other Secrets Lepas Single 'Here to Stay'
Other Secrets rilis single terbaru.
Febrian Adi - Selasa, 06 Juni 2023

Fun
Perlu Adanya Kajian Multidisiplin untuk Produk Tembakau Alternatif
Produk tembakau alternatif perlu dikaji secara multidisplin.
Febrian Adi - Selasa, 06 Juni 2023

ShowBiz
Java Pop Festival 2023 Siap Digelar
Java Pop Festival siap digelar tahun ini.
Febrian Adi - Selasa, 06 Juni 2023

ShowBiz
PERSIS Rilis Jersey Kolaborasi dengan Down For Life
PERSIS rilis beberapa item kolaborasi dengan Down For Life.
Febrian Adi - Selasa, 06 Juni 2023

Fun
Intip Khasiat Rutin Konsumsi Anggur
Ternyata rutin konsumsi buah anggur baik untuk tubuh
Febrian Adi - Selasa, 06 Juni 2023

ShowBiz
More on Mumbles Lepas Single ‘Good For You’ Melalui Sony Indonesia
More on Mumbles lepas single bersama Sony Music Indonesia.
Febrian Adi - Senin, 05 Juni 2023

ShowBiz
Snoop Dogg Tunda Manggung untuk Dukung Para Penulis Hollywood
Snoop Dogg tunda manggung untuk dukung para penulis.
Febrian Adi - Senin, 05 Juni 2023

Fun
Kiat Jalani Hidup Sehat dan Menyenangkan untuk Penyintas Kanker
Kiat untuk jalani hidup tetap menyenangkan bagi penyintas kanker.
Febrian Adi - Senin, 05 Juni 2023
Fun
Raksasa Attack on Titan akan Menyerang Jakarta
Pameran 'Attack on Titan: The Final Exhibition' akan digelar pada 17 Juni 2023.
Febrian Adi - Senin, 05 Juni 2023

Lifestyle
Investasi Emas kian Mudah via Aplikasi
Investasi emas kini makin mudah dengan fitur transfer emas di aplikasi Lakuemas.
Febrian Adi - Senin, 05 Juni 2023
